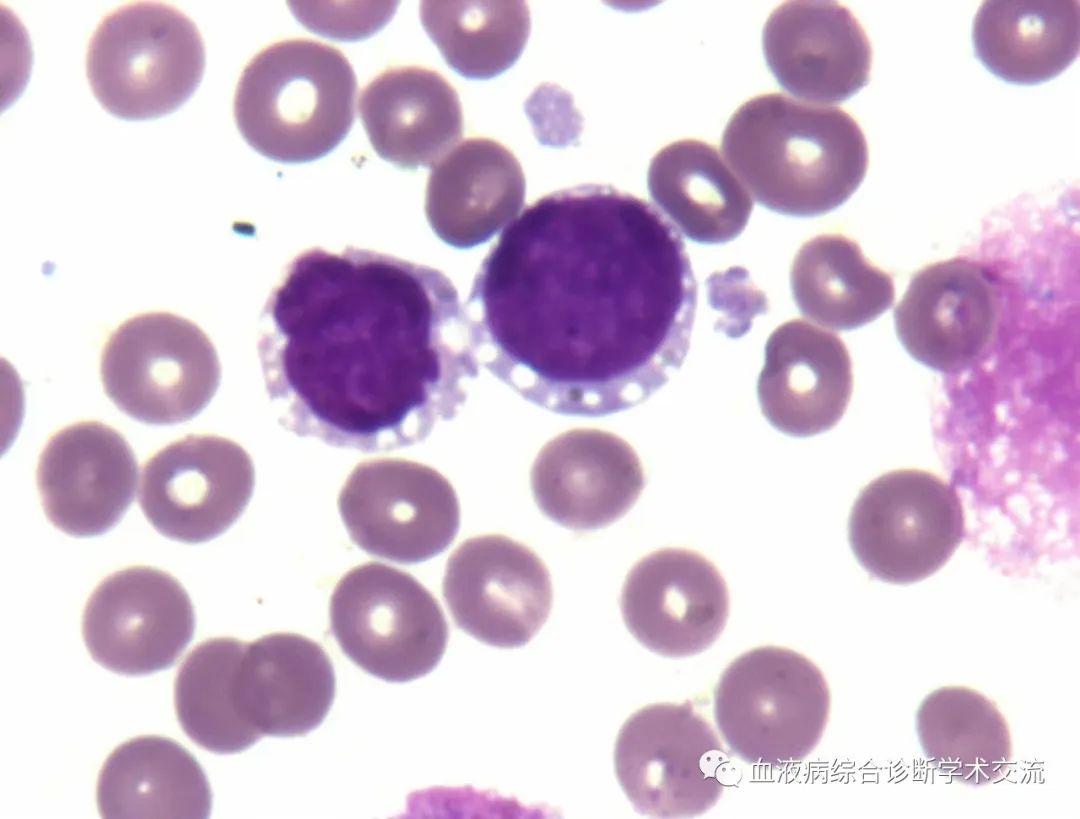

查看更多
密码过期或已经不安全,请修改密码
修改密码
壹生身份认证协议书
同意
拒绝

同意
拒绝

同意
不同意并跳过






作者:徐州医科大学附属医院 王海洋
【病例简介,向下滑动查看更多】

患者,女,58岁,因“20天前无明显诱因下出现头晕、乏力,活动后气促,伴颜面部浮肿”入院。
2021年12月23日胸部影像学检查:左肺上叶示结节影(IM19),大小约12×7mm,边缘示条索影,见血管影进入。
气管及两侧主支气管通畅。纵隔内未见明显增大淋巴结影。
两侧胸腔未见明显积液征象。诊断印象:左肺上叶结节(肿瘤性病变不除外),建议:密切随访,必要时活检。
2022年1月7日胸部影像学检查:两肺散在条索,右肺下叶胸膜下斑片影。
气管及两侧主支气管通畅。纵隔内未见明显增大淋巴结影。两侧胸腔未见明显积液征象。诊断印象:较前片2021年12月23日左肺上叶结节消失。两肺散在条索,右肺下叶少许炎性灶。

血常规:

生化结果:
血涂片瑞氏染色:


骨髓涂片瑞氏染色:

骨髓涂片PAS染色:





骨髓活检报告:
(髂后)送检骨髓穿刺组织2条,长0.4~0.5cm,直径0.2cm,骨髓增生极度活跃(约90%),原始细胞明显增多,少量成熟阶段粒红系细胞散在分布,巨核细胞0-1个/HPF,分叶核为主,待免疫组化进一步诊断,网状纤维染色:(MF-1级)。
染色体核型分析:

病例解析
本例形态学最大的难点在于原始细胞内含有多少不等的空泡,在PAS染色下呈珍珠项链样围绕细胞核排列,且PAS酶型是背景十分干净的基础上出现中粗颗粒、成珠成块阳性,这种酶型多见于淋系肿瘤,尤其是ALL更为多见。亦可见于AML-M7和BPDCN。
ALL、淋巴瘤、BPDCN都是干扰选项。而正确答案是AML-M2。
通过该病例的分享,主要是想告诉大家,在部分AML中,PAS酶型也可以是背景十分干净的基础上出现中粗颗粒、成珠成块阳性,就像酯酶酯酯抑试验(ANAE+NaF)一样,对于急性单核细胞白血病的诊断没有那么特异,酯酶酯酯抑试验阳性也可见于部分AML-M2和ALL患者。
骨髓涂片可见胞浆带空泡的细胞和疾病有:BPDCN、转移癌、DLBCL、MM、Burkitt淋巴瘤、浆巴母细胞淋巴瘤、横纹肌肉瘤、ALL、AML-M0、AML-M1、AML-M2、AML-M5、纯红细胞白血病、AML伴CEBPA双等位基因突变、尤文氏肉瘤、MDS、神经母细胞瘤、肥大细胞增生症、尼曼-匹克病、铜缺乏性贫血、Pearson Syndrome、VEXAS syndrome、泡沫浆细胞、脂肪细胞等,几乎囊括了能想到的常见和少见疾病。
有趣的是该患者存在Ph染色体,且p210阳性,需要鉴别AML伴BCR-ABL1和CML急变。
Ph+原发急性白血病与CML-BP鉴别方法:

骨髓涂片同步瑞氏染色及原位FISH检查对比分析;

FISH检查DAPI染色分析;

流式细胞分选后进行基因检测:CML急变的患者,除了原始细胞外,骨髓粒、红、巨、淋系细胞也同样具有BCR/ABL1基因阳性,而Ph+原发急性白血病,BCR/ABL1融合基因只能在原始细胞群检测到,而其他细胞融合基因为阴性;

如果上述FISH和流式分选做不了。化疗完全缓解后,原发性急性白血病的Ph染色体可消失,BCR-ABL1可以阴性;而CML急变者Ph染色体难以削减,还常伴有附加染色体异常,BCR-ABL1+仍然阳性。
该患者经过化疗骨髓完全缓解后,p210检测阴性,更加支持AML伴BCR-ABL1的诊断。
来源:血液病综合诊断学术交流

查看更多